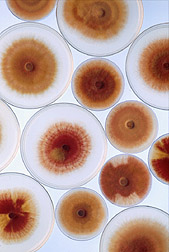

11 Plus Ways to Good Health
11 Plus Ways to Good Health  11 Plus Ways to Good Health
11 Plus Ways to Good Health
Plus Exercise & Supplements
1. Managing Your Sugar
 This
includes sugar from the goodies, sugar conversions from refined grains, bread,
rolls, bagels, potatoes and corn and sugar from booze.
This
includes sugar from the goodies, sugar conversions from refined grains, bread,
rolls, bagels, potatoes and corn and sugar from booze.
Note: Essential Sugar from fruit only in its whole fibrous form, with almost zero straight juices only is preferred. This includes a glass of orange juice with the most pulp split into two glasses with half water and a scoop of whey protein.
You should be able take in an adequate
amount of sugar from 5 fibrous fruit sessions a day as I do, with its fiber
content that slows up the release process of the sugar into the bloodstream and
eliminates negative excessive insulin production. Negative insulin produces a
nasty fatty substance that collects around
your
rump, your heart and the walls of your arteries etc. In addition,
this by product is stored
fat and backs up in your liver as demonstrated disgustingly on your right and
prevents the liver from metabolizing fat, as that is one of the
primary functions of the liver, along with about 500 other vital
functions. A liver that is not functioning to the max is a train wreck
waiting to happen. Fatty meats, sugar and grains that are cooked as in cookies, cakes,
pies etc. are the worst offenders, as food when cooked changes the
molecular structure of the atoms in the food and for some technical reason have
an affinity to attach to areas, like the portals of your heart etc.
Cholesterol by the way is a critical pre-hormone produced and delivered to the
cells 24/7. You need clean Cholesterol from good fats, that converts
to the pre-hormone produced by the liver, sent to the kidneys and in a
revolving door effect continues to nourish the body.
Oxidation of the cholesterols and especially LDL from cooking is the real villain and if you want the champion regarding high heat, barbecuing beats them all, especially fatty meats. You have to be absolutely nuts to barbecue fatty meats and eat it no less.
Fruit sessions can be an apple for one session, cut up fruit in low fat, low sugar yogurt is another. You would want to minimize the sweet vegetables like corn, peas and beets although if you are very active in sports, exercise, walking etc. the sweet vegetables may not have to be sacrificed. The scale is your guide. Simply obtain the sugar that you need from whole fruits and there is some sugar in most of the acceptable vegetables. The more diversified the better.
Dark Chocolate
I had an Aunt that lived to 96 that lived on dark chocolate. Dark chocolate has varying degrees of purity relating to its cacao polyphenol contents. Hershey has a dark chocolate that is 65% pure. Ghirardelli has an 86%. There is chocolate that has higher amounts and many with artificial ingredients that have less. You can well afford to buy the best as the benefits in dark chocolate are huge. My wife and I eat 1 square of the 86% Ghirardelli brand every day.
We also take a supplement from the Life Extension company in Ft. Lauderdale that has Pomegranate and CocaGold derived from the cacao bean. Again the polyphenols have been found to be especially beneficial to the cardiovascular system and endothelial function. We are talking about the walls of your arteries and flow. No question the healthier your cardiovascular system is the better chance of beating the bad news.
Click here for our Bad Sugar feature.
 2. Getting enough Sun.
(But
not too much)
2. Getting enough Sun.
(But
not too much)
There is a mountain of scientific evidence that clearly shows how powerful an influence vitamin D3 is on the prevention and treatment of cancer. Optimal vitamin D3 levels works dramatically in preventing many cancers, especially breast, prostate and colon cancers.
Most of us have vitamin D3 levels that are far too low. The best way to bring these levels back up is by exposing your skin to sunshine, something most of us can and should do in the summer and if you live in the northern areas of the country during the winter, tuck a light aluminum chair outside your door and once that sun comes out even on cold days, lift the pant legs, roll up the sleeves, open the collar and get what you can get, without freezing your tookess off. There is strong evidence that the long-standing recommendation of avoiding sun exposure has increased cancer deaths, not just non-fatal skin cancers, by more than 50,000 per year in the United States due to lowered vitamin D levels.
If you have to depend on Vitamin D from a supplement in addition to sun intake to achieve acceptable levels (over 50 ng/ml check your labels and make sure you obtain the cholecalciferol Vitamin D3 rather than the inferior Vitamin D2 ergocalciferol.
Few foods naturally contain vitamin D. Sardines which have an abundance of important nutrients, including potassium, protein, omega-3 fatty acids, vitamin B-12, iron and calcium in the tiny sardine bones, are a good source of vitamin D. I personally eat 3 to 4 full cans of Sardines a week, about 4.25 ounces at a sitting and in fact for 1 lunch a week I take a full can, chop up the sardines and combine them with a can of Progresso soup either the Manhattan or New England clam chowder. It is delicious treat with all the nutritional trimmings. Vitamin D is best produced by the Sun and the best choice over supplements. Vitamin D has so many benefit we can't even begin to enumerate them, from bone loss to your immune system and in particular your lymphatic system. The sun is an Alzheimer's crusher.
The fact is that Vitamin D dictates not only the absorbability of calcium in the intestines, it controls all the calcium in the bodies functions including the brain. This was our personal practice and learning 101 in our agricultural career. Calcium content in the soil was the microprocessor for all the minerals in the soil and their individual electrolyte functions as well as hormone production.
It has been recently revealed that it is calcium deposits in the brain that could be the responsible villain in Alzheimer's disease. They know it is deposits and calcium is notorious for unwanted deposits. We all obtain calcium in various ways. Some calcium especially where there is an abundance of Vitamin D3 intake and magnesium will be properly absorbed and properly metabolized. This is why I subscribe to Sardine intake with its total compliments. Tuna is a good source of vitamin D and calcium if they do not remove the bones. Most Tuna retains the pin bones (More below)
This process can be easily compared to a combustion engine. Some engines are fine tuned and burn the majority of the fuel it uses. Some engines are out of whack and wastes are produced and accumulated in the engine parts. The body mechanism is not any different. I might say that the type of fuel used in an engine is similar to the fuel we ingest for our engine.
There are situations in bone loss
cases where the body is not obtaining enough calcium and actually cannibalizes
the bone matrix of the patient. This generates a very significant source of
calcium and the nature of this product is devastating to the body and a perfect
storm for unwanted calcium accumulations. I happen to believe this is a
arthritis thread.
3. The Cholesterol connection
We have discussed the Cholesterol connection and its revolving door effect above. As we know the sun and Vitamin D3 plays a huge role in human health. We know that good clean Cholesterol uses Vitamin D3 in the process back at the liver. It can get by with other sources of Vitamin D3 like out of a bottle, but nothing compares to the optimization of the process that the sun provides. It is not how much Cholesterol that your body is manufacturing or taking in that the Doctors are obsessed with lowering, it is the quality of the Cholesterol. The medical establishment bases their Cholesterol lowering advocacy on the fact that their patients gorge themselves with damaged Cholesterol and guess what, they are right. Most people eat too much cooked food and not enough raw.
The question is how should elevated Cholesterol be treated lets say 200 or more in one that keeps their damaged cholesterol at a bare minimum? Is it possible that this could be a serious mistake if it is lowered? I think so!
Damaged CholesterolDue to the influence of heat, cholesterol in food is oxidized. Already at 100°C, cholesterol oxidizes 'spontaneously'. (19) Through oxidation, the cholesterol molecules gain or lose atoms, originating new cholesterol-like molecules.
Due to the influence of heat, approximately 30% of cholesterol oxidizes into oxy-cholesterols. About 6% of oxy-cholesterol is absorbed into the body. (20) ABSORBED INTO THE BODY
Essential Cholesterol
10 to 20% of the brain is composed of cholesterol. Thanks in part to cholesterol in animal food, humans are as intelligent as they are. Essential substances like the sex hormones and vitamin D are also constructed of cholesterol. Therefore it is absolutely not true that a low cholesterol level is healthier.
 Now
here is good question for you. If 20% of your brain consists of essential
cholesterol, do you want to subject it to damaged goods as in damaged
Cholesterol? I don't think so!
Now
here is good question for you. If 20% of your brain consists of essential
cholesterol, do you want to subject it to damaged goods as in damaged
Cholesterol? I don't think so!
"An idle mind is the devil's workshop" And the devil's name is Alzheimer's.
Does it take a brain surgeon no pun intended, to come to the conclusion with all the facts above that Alzheimer's is linked to the way your foods are prepared or how they are not prepared? EAT RAW
Interesting feature on Cholesterol
http://www.13.waisays.com/cholesterol.htm
Click here for our Sun and You feature.
 4.
Balancing your Omega essential fatty acids (6s and 9's) with a weighted amount of
Omega 3's or more.
4.
Balancing your Omega essential fatty acids (6s and 9's) with a weighted amount of
Omega 3's or more.
If you want to prevent cancer, heart disease and most ills it is important to work on increasing your ratio of omega 3's over omega-6 and 9 essential fatty acids and in the process balancing your good bacteria against the bad.
Before you concern yourself with balancing, you must address obtaining enough of the Omegas and enough of the right kinds of probiotics.
Most nuts, seed, vegetables, olive oil etc. have a blend of omega 3, 6 and 9 essential fatty acids. They are called essential because they are. If you stay away from the cheaper oils in baked goods, the whites etc. obtain enough omega 3's as stated below, you will achieve the desired ratio of 3's over the 6's and 9's.
Life Extensions in Ft. Lauderdale has a good Omega 3 fish oil capsule supplement with sesame lignans added to prevent degradation. This is because the Omega-3's in fish are high in two fatty acids crucial to human health, DHA and EPA. There are other good sources of Omega 3's, although the marine sources from fish, Salmon, Tuna, Sardines and their oils have unique properties over the other omega 3's.
Other good sources of 3's are dark leafy vegetables, (Spinach is the king of them all, on of the highest amounts of anti-oxidants) freshly ground flax seed and their oils and walnuts in particular have a weighted amount of Omega 3's as well as 6's and 9's. Surprisingly walnuts have a generous amount of lycopene, usually associated with fruits and some vegetables. Omega 6's and 9s are also essential as stated above and worth repeating, as long as you don't rely on fats from oils in baked goods, cookies, cakes etc. with their unhealthy Trans Fatty acids to provide them.
Below
is a link into a Harvard study on good fats and bad fats and their links pros
and cons to excess cholesterol in the blood stream, that can cause plaque
build up. Ironically it is critical to have a sufficient amount of fat and
cholesterol in your blood stream. The white substance flowing through your
lymphatic network or as Hippocrates called it "white blood" is made up in part
of fat, as fat is the transporting vehicle of nutrients and wastes.
Low fat commercialism is an injustice and the government should address this.
The trick is countering any build up of bad fats with the good fats that clean out the arteries, heart and liver. This Harvard study is a must read if you want to make old bones and understanding the subject matter.
http://www.hsph.harvard.edu/nutritionsource/fats.html
Probiotics is a complicated subject and I am not going to even attempt to tackle the subject, other than the facts that gut flora breaks down food that remains after it is digested earlier and incorporating the right probiotics discourage harmful bacteria and yeasts from invading the body.
Commercially fermented milk products as in yogurts are one of the best sources of probiotics. Apple cider vinegar and the mystery of centuries surrounding it I believe is relative to the fermented nature of it. Sauerkraut not only being derived from cabbage one of the finest foods you can eat, but add to it sauerkrauts fermented state makes it an excellent probiotic. Pickles another good probiotic and especially salted gherkins. There are supplemental probiotics that we may in time take. For now we are going to rely on foods to provide our needs although we do take a digestive enzyme supplement.
Click here for our Tissue Acid Waste feature.
 5. Eating the right proportion of
Alkaline forming foods vs. Acid
forming foods (80% to 20%)
5. Eating the right proportion of
Alkaline forming foods vs. Acid
forming foods (80% to 20%)
We have written extensively in different features on our website regarding the importance of eating a diet predominately alkaline. Of course an alkaline diet corresponds to a clean cholesterol. Our Condensed information on health feature, our Alkalize feature, pH feature, Tissue acid waste feature, the list is long and the evidence is indisputable. I can't help thinking of a friend that is going through Chemo right now with Lymphoma and reading about the Lymph network and the importance alkalinity plays in it. Of course the king of alkalinity is fruits and vegetables and should be served at every meal and snack. In addition to the fruits in our morning cereal we serve on the main plate of lunch and supper many servings of fruits and vegetables. Add to this our mid day "snack" of an afternoon smoothies that is loaded with fruits and vegetables.
Click here for our Alkalize feature
 6. Balancing each meal and snack with an equal proportion of
Carbohydrates, Protein and Fats 40-30-30 is optimum.
6. Balancing each meal and snack with an equal proportion of
Carbohydrates, Protein and Fats 40-30-30 is optimum.
I received my first education from the Daoust couples 40-30-30 book on balancing the big 3 when I undertook a 30 lb. weight loss program and boy did it work like a charm. We all know obesity kills you, what most don't know that even that little potbelly is like a roadside bomb. I have followed this program religiously even after achieving my 30 lbs loss. For over 3 years now there has only been two instances when I grabbed an apple and ran that I did not adhere to eating a balance at every meal and snack. One example: My mid-afternoon snack.. an apple (the carbs) a few pieces of chicken ( the protein) and a palm full of nuts (the all important good fat). I believe it has helped me to maintain my optimum weight and I believe there is a relationship between weight, storing fat and also the storing of tissue acid waste that I call the "Serial killer". Balancing every meal and snack and of course observing calories, stimulates the production of the hormone Glucagon. Glucagon is the fat and I believe the tissue acid waste burning hormone especially if you observe the alkaline/acid balance detailed in the last feature above. Tissue acid waste needs alkalinity for a catalyst effect.
The premise of this feature involves the proven aspects of the hormone Glucagon being the fat burning hormone and the theory of our own that believes the same body fat burning powers of the hormone Glucagon, has the same powers to clean your arteries from fatty plaque and have a likewise positive effect on the lymphatic network.
Glucagon in the process regulates sugar and keep in mind that the only fuel cancer needs is sugar. If you deprive your system of excess sugar you deprive the fuel that cancer needs to proliferate. My God if you have cancer or the pre cancerous symptoms as in pap smears etc. regulate your sugar. You regulate your sugar by producing Glucagon versus Insulin and a 40-30-30 balance at every meal and snack will do the trick. One of my favorite balance snacks is a glass of high pulp orange juice (the carbs) with a scoop of whey protein ( the protein) with a nice bunch of pumpkin seeds (the fat). An example of a lunch will be a salad with raw green vegetables, cut up fruit and berries (the carbs) with 3 to 4 ounces of Omega 3 sardines (the protein) mixed with some nuts, walnuts, etc. topped off with extra virgin olive oil (the good fats) Most lunches we have a dish of water melon that adds to the carbs and a dish of yogurt with nuts and some fruit.
Note: We are working in a smoothie in lieu of the afternoon regimen. It incorporates the principles of the 40-30-30 benefits. The smoothie link is
http://www.blueeyedcurse.com/smoothies.htm
Connecting the Dots
In connecting all of the dots recently , we arrived at a conclusion that the same program in losing weight will present your body and primarily your blood and in particular your lymph system with the same abilities that burns fat off of your hide but it also in the same process have an incredible ability to not only clean your fat laden plaque ridden arteries, but also in the process optimize your lymphatic system. You have thousands of miles of lymph vessels that need cleaning.
Exercises to move the Lymph fluid
You also need a modest exercise program to move lymph fluid. The fellow above is moving fluids in an out of his upper extremities. Notice the stretch on some of these exercises in his neck and clavicle areas. That is where a host of lymph nodes reside.
 Insulin is produced when your intake is heavy in carbohydrates
and in particular high sugar foods. Insulin is the fat storing and waste
storing hormone and that is good if you are going to go into hibernation as a
bear does for months at a time. This is what the fat storing process was
designed for. Surviving from one winter to another took precedence over
leading a long life without tissue acid waste terrorizing your body.
Insulin is produced when your intake is heavy in carbohydrates
and in particular high sugar foods. Insulin is the fat storing and waste
storing hormone and that is good if you are going to go into hibernation as a
bear does for months at a time. This is what the fat storing process was
designed for. Surviving from one winter to another took precedence over
leading a long life without tissue acid waste terrorizing your body.
Now there is a significant area of
interest regarding low carb diets. Atkins recommended almost nothing in
carbs for at the least the initial
 start of his weight loss program. It
has been discovered that eliminating most carbs could be dangerous even for
short periods, as without adequate carbs to fuel your body the body does
eat on the fat to provide the energy. There is nothing wrong with that as
fat is the bodies preferred energy source, but not to eliminate carbs for
energy sources as well. Just depending on animal fats and protein as an
energy source generates a waste product call ketones and these are some of the
worst free radical buggers that you can have roaming around in your body.
start of his weight loss program. It
has been discovered that eliminating most carbs could be dangerous even for
short periods, as without adequate carbs to fuel your body the body does
eat on the fat to provide the energy. There is nothing wrong with that as
fat is the bodies preferred energy source, but not to eliminate carbs for
energy sources as well. Just depending on animal fats and protein as an
energy source generates a waste product call ketones and these are some of the
worst free radical buggers that you can have roaming around in your body.
The weight watcher program that
advocates as many as 5 fruits a day is more realistic to me to obtain the right
carbs, but not in excess, so that
 you still can burn off some of
that fat. Of course everything hinges on your level of physical activity.
I personally have no problem indulging a couple of times of week in pasta,
one of the infamous "whites" although we try to stay with the better
quality pastas. I know that this food will convert to sugar
and I will burn it off in my very active sports and gardening activities.
When the day comes that I have to reduce these activities I will have to make an
adjustment. As long as I get up in the morning and my 6'2'' frame weighs
in at 170 I am happy and I will leave sleeping dogs lie at that.
you still can burn off some of
that fat. Of course everything hinges on your level of physical activity.
I personally have no problem indulging a couple of times of week in pasta,
one of the infamous "whites" although we try to stay with the better
quality pastas. I know that this food will convert to sugar
and I will burn it off in my very active sports and gardening activities.
When the day comes that I have to reduce these activities I will have to make an
adjustment. As long as I get up in the morning and my 6'2'' frame weighs
in at 170 I am happy and I will leave sleeping dogs lie at that.
Click here for our feature on 40-30-30.
 7. Drinking enough fluids
during the day and drinking the right mix.
7. Drinking enough fluids
during the day and drinking the right mix.
Most people do not drink enough
fluids.
There are volumes and volumes of medical information regarding the bodies needs
of adequate hydration and the elimination of wastes. Now there
has been written pros and cons regarding distilled water. I personally
have drank distilled water for over 40 years now, starting with my concern
of the percolation of hard agricultural chemicals into our wells on our farm and
around our home there. This was followed in Florida where our water source
is treated and it needs to be treated as bacteria in water is common. Unfortunately chlorinated water
taking care of the bacteria in it, takes care of all bacteria in the gut and
this is not good as we need certain bacteria's working in our gut. Most
municipal water has a certain amount of beneficial minerals that comes from
ground water. There has been some bad press regarding plastic containers
and water. There is question regarding Coca Colas Da Sani brand. The
last thing Coca Cola and their bottled water enterprise would need is bad press
on their water, so my guess is they are very quality control
 oriented.
Another avenue is spring water and the Giant Nestle company has their
Zephyrhills brand. Again I would be astounded if Nestle would allow something to
slip through the cracks. I would say the same applies for the other large
bottled water suppliers. In fact if the only source of water rather than
distilling your own was bottled water I would go along with a popular spring
water. Nestle's Pure Life Purified Water is the latest approved spring
water. I am not sure the difference between this product and the
Zephyrhills brand.
oriented.
Another avenue is spring water and the Giant Nestle company has their
Zephyrhills brand. Again I would be astounded if Nestle would allow something to
slip through the cracks. I would say the same applies for the other large
bottled water suppliers. In fact if the only source of water rather than
distilling your own was bottled water I would go along with a popular spring
water. Nestle's Pure Life Purified Water is the latest approved spring
water. I am not sure the difference between this product and the
Zephyrhills brand.
I am very apprehensive about buying
distilled water in dubious plastic containers, simply based on the integrity of
the material in the container and distilled water being a solvent in
itself with the chances of
 picking up the plastic residue
perhaps left over from the manufacturing process. The containers
you find in the super markets look flimsy, they look weak, cheap is a better
word. Now someone could straighten me out about this perception. On
the other hand the bottles in the better waters from the larger suppliers appear
to me that they are very conscious of container residue and pay more for quality
containers and pass this on to the consumer. These better containers look
more
impervious, what do you think?
picking up the plastic residue
perhaps left over from the manufacturing process. The containers
you find in the super markets look flimsy, they look weak, cheap is a better
word. Now someone could straighten me out about this perception. On
the other hand the bottles in the better waters from the larger suppliers appear
to me that they are very conscious of container residue and pay more for quality
containers and pass this on to the consumer. These better containers look
more
impervious, what do you think?
Distilled water takes everything out of the water and this
is not good especially if you subscribe to a diet alkalizing regimen as I do.
The solution is simple. Spike the distilled water with natural sources of
alkaline minerals. We
use lemon juice a couple of squirts in a quart, a tablespoon of Braggs apple
cider vinegar and we put in a shot of pure cranberry
juice, the Lakeside brand, all in about a quart
to a half a gallon of
distilled water to drink before during and after a workout. A little baking soda
could be smart. Just a dash. A sprinkle of Paprica with its high
concentration of Potassium would be a nice addition. We use it in our
water every day. A glass of distilled water at a meal or snack can
have either Green tea mixed with it, or a squirt of lemon juice. We rarely
drink distilled water straight. The kidneys need water for flushing,
but it is the natural minerals in the water that does the trick. We are
talking an array of minerals that scavenge the impurities. This is the
principle behind a high natural alkaline diet regimen because an acid regimen
works in reverse, hence tissue acid waste. The Nepalese tribe in the Himalayas
drink water coming down from the mountain side that is the color of milk it is so
alkaline. Most of these dudes live into their hundreds. Spiking
distilled water with natural bi-carbonates etc. is just a great means to
increase your alkalinity intake.
Keep learning. Learn more about the computer, crafts, gardening, take tennis lessons even if you are 90 whatever. Keep well alkalized with the right foods and water. Never let the brain idle. "An idle mind is the devil's workshop." And the devil's name is Alzheimer's.
 8. Understanding and Maintaining
your Lymphatic Network.
8. Understanding and Maintaining
your Lymphatic Network.
We have recently come across a dramatic piece of research concerning health and one that we have been completely ignorant of. The fact that lymphatic fluids carry nutrients to our cells and removing wastes in the process was all new to us and fascinating. We certainly were astounded to discover that there is more lymphatic fluid in the body than blood, in fact three times as much. Hippocrates the Father of medicine called it “White Blood”.
 The mini-trampoline subjects the body to gravitational pulls ranging from zero at the top of each bounce to 2 - 3 times the force of gravity at the bottom, depending on how high the person is rebounding. Unlike jogging on hard surfaces which puts extreme stress on certain joints such as the ankles and knees eventually damaging them, rebounding affects every joint and cell in the body equally.
The mini-trampoline subjects the body to gravitational pulls ranging from zero at the top of each bounce to 2 - 3 times the force of gravity at the bottom, depending on how high the person is rebounding. Unlike jogging on hard surfaces which puts extreme stress on certain joints such as the ankles and knees eventually damaging them, rebounding affects every joint and cell in the body equally.
Take particular note of the bar that canopies the trampoline. When we bought the trampoline we declined the bar. This was a mistake. My youngest daughter broke her arm on a trampoline when she was a youngster. I soon realized that when using it without a bar, the unsteadiness prevented me from getting up as high as I would like. The bar also keeps me in the center of the device. Don't buy a trampoline without the bar, trust me.
Caution
Note: We have had recent professional advice regarding the bar and trampoline. Grasping the bar with a firm grip could be a deterrent to creating the gravitational benefits we refer to. Keeping your fingers within close reach of the bar and using the bar when there is a momentary destabilization issue is advisable. In other words hang loose. Let the body do its thing from head to toe and minimize holding on to the bar as much as you can safely do it.
In addition, jumping as high as you can off of the mat could be the ticket for young folks and athletes but could be a negative for elderly and create muscular and even skeletal problems. Start slow with minimizing the lift distance off of the mat. Elderly folks can effect a great deal of benefit by lightly bouncing on the mat with little to no lift off. Let your body be the guide.
Now there is a problem when installing the bar. There is a sleeve on the bar that is attached to the leg of the trampoline. The problem is when you receive the device the rubber feet are installed on the legs of the trampoline and there are two that must be removed to put the sleeves on. They don't tell you but these rubber legs are next to impossible to remove. They tell you to use your thumbs and push them off. I couldn't do it and resorted to taking a utility knife and making a slice about halfway up the rubber leg. (From the open end down) With this done I was able to slide the feet off. After I did this I took some black rubber tape and ran it around the slices a few times. It is under the trampoline and you can't even notice it.
Rebounding may be used effectively in conjunction with niacin use to help detoxify fatty tissues.
My favorite form of exercise is rebounding on the mini-trampoline.
The typical rebound mini-trampoline is about 3' in diameter and 9" high. It is safe, easy to use, and effective. Research has led some scientists to conclude that jumping on a mini-trampoline is possibly the most effective exercise yet devised by man, especially because of the effect rebounding has on the lymph in the body. Most importantly, rebounding is FUN, so we stick to it! Have you ever noticed how children naturally enjoy jumping on a bed? Just as the astronauts experience while floating in space, your body is in a state of weightlessness at the top of the bounce.
The human body needs to move. The lymph system bathes every cell, carrying nutrients to the cell and waste products away. Contrary to blood which is pumped by the heart, the lymph is totally dependent on physical exercise to move. Without adequate movement, the cells are left stewing in their own waste products and starving for nutrients, a situation which contributes to arthritis, cancer and other degenerative diseases as well as aging. Vigorous exercise such as rebounding is reported to increase lymph flow by 15 to 30 times.
Adults can start with
2 minutes of rebounding and increase their time as their fitness level improves. (It is a little tough on the legs when you first start) It's necessary for older people to start gradually in order to give the connective tissue holding the internal organs in place time to strengthen. This prevents the possibility of "prolapsed organs" - the only contraindication to rebounding reported in the medical literature. Therefore increase your rebounding time gradually.Inactive seniors find that gently jumping on a mini-trampoline gives them renewed vigor and zest for life. Hyperactive children are reported to calm down after a few days of rebounding. Rebounding is for everyone and people can use the rebound mini-trampoline whenever they have a few minutes during the day.
The lymph fluid moves through channels called "vessels" that are filled with one way valves, so the lymph always moves in the same direction. The main lymph vessels run up the legs, up the arms and up the torso. This is why the vertical up and down movement of rebounding is so effective to pump the lymph.
Lymph is a clear milky like fluid that travels through your body's arteries, circulates through your tissues, delivers nutrients etc. and on the same trip cleanses them, then drains away through the lymphatic system to the lymph nodes and eventually to the disposal areas of the body. Just incredible!!! Keep in mind that one of the major disposals of the body is in the largest organ of the body, the skin. With the lymphatic system reaching into every cell of the body, it only stands to reason that the health of your skin plays a major role in how efficient acids are eliminated by this vital organ.
We have a feature Aloeplus 8 in our website that involves an off the shelf cream with Aloe Vera Barbadensis gel from our own Aloe plants in the garden and we incorporate about 8 known beneficial antioxidants for the skin into the mix. We go through the whole process of growing Aloe Vera, and preparing the mix and it is free. The direct link is...... http://www.blueeyedcurse.com/apbook.htm
Incidentally this practice of
keeping our skin healthy also allows us to take in a generous amount of sun,
about 30 minutes a day, (not the middle of the day) the body turning in 4
directions and you already have read above read how critical the suns role
is in actually preventing skin cancer, if managed properly. Besides
the information on the sun in this feature we have a special feature on the sun
and the link is.....
http://www.blueeyedcurse.com/sun_and_you.htm
Lymph
nodes are the filters along the lymphatic system. Their job is to filter
out and trap bacteria, viruses, cancer cells, and other unwanted substances, and
to make sure they are safely eliminated from the body There is a question
as to the role of the lymph nodes. There are those that claim they are
just the garbage cans, the distribution centers before being relayed to the
bodies elimination apparatus. I happen to believe that the lymph nodes
serve as a processing area and in fact we have recently had an experience in our
family where a member was being treated for a bunch on her butt and the
accelerated treatment, a mild manipulation using (Lymphatic
drainage) could have been instrumental in provoking a urinary infection.
Lymph
nodes are the filters along the lymphatic system. Their job is to filter
out and trap bacteria, viruses, cancer cells, and other unwanted substances, and
to make sure they are safely eliminated from the body There is a question
as to the role of the lymph nodes. There are those that claim they are
just the garbage cans, the distribution centers before being relayed to the
bodies elimination apparatus. I happen to believe that the lymph nodes
serve as a processing area and in fact we have recently had an experience in our
family where a member was being treated for a bunch on her butt and the
accelerated treatment, a mild manipulation using (Lymphatic
drainage) could have been instrumental in provoking a urinary infection.
We have a special feature on the lymphatic network and especially with a few minutes a day how you can prudently enhance the flow of lymphatic fluid and prevent the malfunctioning of your lymph nodes. The process is called Lymphatic drainage through manipulating the key lymph nodes area with a gentle massage first to clear them, then using either a wash cloth or special brushes to brush the skin and lymph vessels toward the freshly cleared filters of the lymph nodes. The link is below, it's free and if you like you can pass it on the anyone. Holler it from the roof tops if you like....
http://www.blueeyedcurse.com/Lymphnew.htm
9. Exercise
There are many many books written on it. We just can't eliminate exercise from this feature though, because of the importance of it. There are anaerobic (the resistant exercises) like weight lifting without the use of oxygen and there are the aerobic exercises like walking or running that get the old heart pumping and the utilization of oxygen. Actually I have read that walking, one of the best exercises can be a good combination of the two types above. Without going into much detail I will give you a short illustration of my exercise regimen in the photo to the right. Before doing about 20 minutes total using the 4 units shown , I do some light stretch exercises and then I move on to the units. I try to stretch just about every joint and muscle in body in the preliminary exercise before going the heavy stuff that really in not that heavy.
To
the right we have a Jakes AB and Back unit, we do 25 each of 4
different body contortions with Jakes. Next sitting on the seat is what I call a horse is two barbells, 10 pounders.
About 50 motions with the barbells. The horse is one of these leg and pull
affairs, 25 of these is all I can take of that. The whole deal
ends with 5 minutes on the treadmill in the foreground and the last minute or
two I really stress stretching the Achilles tendons along with a heel and strike
operation in my stocking feet. (Information on bone loss and heel and strike
below.) I have had a few buddies pop these tendons before being hauled off to
the operating room. Again I don't go nuts on this equipment, but I
feel it is important to get limbered up before I hit the wars of a paddleball
court 5 mornings a week for about 2 hours of play, fun, perspiration and
getting that heart up a notch. I am sure there are exercise people that
could improve my regimen, but quite frankly I am satisfied with the
results. All of these devices are in the isometric area of workout and we
believe it enhances the critical flow of lymphatic fluid. If you haven't
read our feature on the Lymphatic network
http://www.blueeyedcurse.com/Lymphnew.htm
Mechanical vibrations lead to better bone health and involves a sensing system that's built right into your bones. Within each bone is a series of tiny fluid-filled channels (the canalicular system) which detects the vibrations and passes the signal onto the osteocytes—the bone building cells of your skeleton. These cells are the main architects of new bone, and the more stimulated they get, the more bone they build.
We just had one of the dearest
paddleball players of all time die recently. Hammering Hank Hensch, ex Sea
Bee, Policeman, Fireman my dearest friend. He had
 a
major heart attack. He was a relatively thin individual and very
active all of his 82 years. He
a
major heart attack. He was a relatively thin individual and very
active all of his 82 years. He
 didn't
lack for cardiovascular exercise. He had a recent hip replacement.
Now my understanding is that these operations are followed with blood thinners
to prevent clots. I believe these thinners can promote clots as well by
dislodging accumulated matter in the body. This I believe is what
happened to Hank. If you want to avoid the problems associated with these
operations go back and review the material above on bones and bone
building, and then hit the material on the sun below.
didn't
lack for cardiovascular exercise. He had a recent hip replacement.
Now my understanding is that these operations are followed with blood thinners
to prevent clots. I believe these thinners can promote clots as well by
dislodging accumulated matter in the body. This I believe is what
happened to Hank. If you want to avoid the problems associated with these
operations go back and review the material above on bones and bone
building, and then hit the material on the sun below.
Below is an excerpt from our Sun and You feature. With the relationship of the sun, vitamin D, calcium, bones and bone deterioration that can be one of the cruelest maladies all, ranking right up there with cancer and heart disease, it doesn't take much of a connection with the above tragedy that resulted with my friend Hank and the blood clot problem above.
Michael Holick, M.D., PhD, is one of the world's
foremost authorities on vitamin D and a full Professor of medicine, dermatology,
biophysics and physiology at the Boston University School of Medicine
According
to Dr. Holick, “The notion that we have to protect ourselves from the sun all
the time is misguided and unhealthy.” And people who don’t get enough sun
exposure are at the greatest risk of being deficient in vitamin D. Dr.
Holick gives some ominous warnings that Americans irrational fear of the sun
is causing thousands upon thousands of premature deaths each year. He supports
his warnings with clear-cut evidence from numerous epidemiological studies.
For instance, just a few study findings
show that:
27,500 American
women die prematurely every year from breast cancer caused by vitamin D
deficiency, and according to Dr. Holick’s calculations 55 American women die
prematurely every year from breast cancer caused by underexposure to sunlight
for every one woman who dies prematurely from overexposure to sunlight
(non-melanoma skin cancer).
37,000 men die
prematurely each year from prostate cancer, and this means that 55 to 60 men may
die prematurely from underexposure to sunlight for every one that dies
prematurely due to overexposure. You are three times less likely to die of colon
cancer if you have healthy levels of vitamin D (20 ng/ml or more).
The compound we call vitamin D can no longer properly be considered a vitamin. For most mammals, it is not in any sense even a nutrient. Nevertheless, vitamin D resembles true vitamins inasmuch as humans -- who are cut off from the critical solar ultraviolet wavelengths by reason of latitude, clothing, or shelter -- depend on an external source of the substance, just as they do for the true essential nutrients.
11. Fiber
 We
start this feature out with a short piece of information on fiber, insoluble and
soluble and how it relates to the food components in the main feature below.
There are a great deal of misconceptions regarding fiber in the diet and
supplements and a study in it self. Most foods have a combination of
soluble and insoluble properties and one example is flax seed that has about
half and half and this depends on how it is managed.
We
start this feature out with a short piece of information on fiber, insoluble and
soluble and how it relates to the food components in the main feature below.
There are a great deal of misconceptions regarding fiber in the diet and
supplements and a study in it self. Most foods have a combination of
soluble and insoluble properties and one example is flax seed that has about
half and half and this depends on how it is managed.
When you eat flax seeds without running them through a high speed blender or a coffee grinder the amount of soluble properties go down the drain, no pun intended. In fact eating flax seed without any processing certainly lends it to close to a 100% insoluble food that has some benefits but not gaining the benefits of releasing the on board properties within the seed capsule.
Fruits and vegetables depending on the variety have both properties and especially the soluble properties that are converted to a gel that traverses through the intestines, sponging excess cholesterol and a host of other wonders to the body. We believe that the quality of the gel is determined by what you eat and how it is prepared, therefore what you eat and how it is managed will determine the efficiency factor of the fiber foods that pass through your digestive track.
The smoothie is a tool that releases encapsulated nutrients in all foods and yet retaining the insoluble properties and benefits. The fact that a high speed blender reduces the size of the insoluble properties is not a negative and in fact can be beneficial in the journey process through the digestive process.
Vegetables and fruits are healthy sources of insoluble fiber but again there is soluble properties in fruits and vegetables as well. This is why raw fruits and vegetables are the perfect fiber food. However, no fruit or vegetable contains as much insoluble fiber as grains. Vegetables that have a high amount of insoluble fiber include broccoli, artichoke, Brussels sprouts and carrots. A one-half cup serving of cooked Brussels sprouts has 1.5 grams of insoluble fiber. Fruits with a generous amount of insoluble fiber includes citrus fruits, bananas, peaches, pears, plums, nectarine and prunes. Apples and blackberries are among the best fruit sources of insoluble fiber, with 3 grams in a serving. Again let me stress that these items depending on how they are managed, chewing well is one big factor, will determine the ultimate ratio of soluble and insoluble content derived from the product.
Many legumes are also a great source of insoluble fiber. Legumes, which include beans, peas and lentils, are healthy because they contain a number of essential nutrients. Some legumes that have insoluble fiber include black, kidney, Lima, navy and pinto beans. Cooked peas are also high in insoluble fiber, containing 5 grams in one-half cup serving. Lentils have 7 grams of insoluble fiber in one-half cup serving.
Both insoluble and soluble fiber should be an important part of your diet. Nutritional labels usually do not specify what type of fiber a particular food item contains but they do list the total fiber content. Try to eat enough of both types of fiber to meet your daily recommended amount. Men under the age of 50 should consume 38 grams of fiber per day. Women in that same age bracket need 25 grams of fiber each day. Men older than 50 should get 30 grams a day. Women over the age of 50 should consume 21 grams of fiber per day.
Now what that optimum ratio will be can be monitored by observing your bowel habits and content and below is a link to a Dr. Mercola feature on this issue. If you haven't signed up for Dr. Mercola's health information don't hesitate as it is the best free bargain on the Internet on health issues.
The below Mercola link has to be copied and pasted into your address line.
http://articles.mercola.com/sites/articles/archive/2013/02/14/normal-stool.aspx
A gradual beginning
The best way to put together an exercise routine that revs up this bone-stimulating system is to work with your physician and therapist. Of course the lower your bone density score, the more cautious your initial exercise program will be.
If your bones are fragile enough, the first phase of your program may avoid
weight-bearing exercises and have you lie on the mat for a few weeks of
stretches and exercises in order to strengthen the core muscles of your lower
back and abdomen that support your spine. Only when these are in good shape will
you be ready for weight-bearing exercises that involve your arms and legs.
Good Vibrations
Though weight-bearing exercise is key to maintaining bone density, the concept is often misunderstood. You don't need barbells or weight machines. What you need is a heel-strike exercise that sends a regular and repeated vibration up through your heel to your legs and spine. And you can get this from walking, climbing stairs, or aerobics.
Lymphatic Drainage and Exercise
Incidentally when you review our feature on the lymphatic network, you will see how important exercise is for lymphatic drainage. Just expanding your chest to the max as well as all isometric exercises is the dynamics behind lymphatic flow, as the lymph system does not have the benefit of a pumping heart.
Mineral and Supplements
As
in exercise I am not going tag a number on this important issue. This will
be like an appendage.
There is a raging
debate going on regarding the importance of minerals and supplements. On one
side you are told if you eat a good balanced diet you don't need to
supplement. The other side says that they cannot rely on adequate
nutrition from our depleted soils and the standard fertilizers, Nitrogen,
Phosphates and Potassium although they will produce a crop and in some cases
with acceptable yields, they just do not have the micronutrients that we
need to feed our bodies sufficiently. There are some fertilizers with
 micronutrients
that attempt to fill this gap, we used micronutrients in foliage feed aerial
applications on our crops for years and in most cases we received good results
as far as yield etc. but we never bothered to examine our crops for the
nutrients passed on to the consumer, within these crops. One example
was applying a potassium concoction a week or so before harvesting sweet corn
and obtaining a much higher amount of sugar in the corn. Of course now we
are hearing about genetic engineering of plants and I am not even going to go
near this subject. This was after my time and I am more nervous about this
than I am about supplements.
micronutrients
that attempt to fill this gap, we used micronutrients in foliage feed aerial
applications on our crops for years and in most cases we received good results
as far as yield etc. but we never bothered to examine our crops for the
nutrients passed on to the consumer, within these crops. One example
was applying a potassium concoction a week or so before harvesting sweet corn
and obtaining a much higher amount of sugar in the corn. Of course now we
are hearing about genetic engineering of plants and I am not even going to go
near this subject. This was after my time and I am more nervous about this
than I am about supplements.
So it is obvious what side of this debate we come down on. We believe in supplements and we use them regularly, but not in excess. We go out of our way to stay below the Federal guidelines on most of our intake. In fact we take a day off (Sunday) for a sabbatical and eliminate all supplements for the day. In another words we are just giving our system a break and allowing it to clear out so to speak and start anew on Monday morning.
In regard to
depletion of the soils. I am a Long Island boy and in fact I
 read
a history book last summer where it referred to the farmers of Long Island
serving and in some cases collaborating with the British when they landed on
Long Island in the late 1700's on their way in invading the City of New York.
Long Island has been known for potatoes for centuries now on the same land.
Sure they plow down cover crops and rotate as well as pour on fertilizers,
but you can't help thinking that there has to be something lacking in the crops
they produce.
read
a history book last summer where it referred to the farmers of Long Island
serving and in some cases collaborating with the British when they landed on
Long Island in the late 1700's on their way in invading the City of New York.
Long Island has been known for potatoes for centuries now on the same land.
Sure they plow down cover crops and rotate as well as pour on fertilizers,
but you can't help thinking that there has to be something lacking in the crops
they produce.
 We
have a theory regarding our intake and our intake is very high in antioxidants
and minerals via fruits, vegetables, nuts and seed as well as the good oils as
in olive oil. We believe a moderate amount of supplements taken with a
good balanced diet compliment one another and if there is an excess amount of
these components that the body will rely on it's protective mechanism, "It
takes what it needs and gets rid of the rest". It is entirely possible
that with a balanced diet there may be little benefits from supplements,
but rather than take a chance we indulge in supplements.
We
have a theory regarding our intake and our intake is very high in antioxidants
and minerals via fruits, vegetables, nuts and seed as well as the good oils as
in olive oil. We believe a moderate amount of supplements taken with a
good balanced diet compliment one another and if there is an excess amount of
these components that the body will rely on it's protective mechanism, "It
takes what it needs and gets rid of the rest". It is entirely possible
that with a balanced diet there may be little benefits from supplements,
but rather than take a chance we indulge in supplements.
For
those who may still feel an apprehension regarding "overdosing" we rely on
a yardstick in monitoring our urine pH. If our urine pH stays within the
6.5 to 6.75 range we know we are not overdosing on alkaline foods or
supplements. These readings also insure we are not running acid as pH
readings especially in the morning on the first catch around 6.0 or under can be
an indication the kidneys are over burdened, and cannot neutralize the acids
imposed with a poor acid producing diet. This marker by the way will tell
anyone that they may be overdosing not on supplements but the wrong acid
producing foods.
We have written in
some of our other features about the sophisticated nature of the waste products
that we naturally manufacture/retain from just exercise (lactic
acid). Even good nutritional foods along with some
 of
the bad ones that we discuss produce free radicals, oxidants etc. and cannot be
avoided entirely. Free radicals by the way are the bodies serial killers
and they too are very complex sophisticated hombres. You know Willy Sutton
the notorious bank robber that was asked why he robbed banks said "Because that
is where the money is". Now Sutton was very sophisticated in his trade and
they needed sophisticated methods to collar him. The same is true for
these free radical renegades with missing electrolyte parts roaming your body.
If they had all of their marbles they would be easily scavenged by most any
dietary regimen. Instead the only way you are going to pick them up is
with a full arsenal. I call it fighting with fire.
of
the bad ones that we discuss produce free radicals, oxidants etc. and cannot be
avoided entirely. Free radicals by the way are the bodies serial killers
and they too are very complex sophisticated hombres. You know Willy Sutton
the notorious bank robber that was asked why he robbed banks said "Because that
is where the money is". Now Sutton was very sophisticated in his trade and
they needed sophisticated methods to collar him. The same is true for
these free radical renegades with missing electrolyte parts roaming your body.
If they had all of their marbles they would be easily scavenged by most any
dietary regimen. Instead the only way you are going to pick them up is
with a full arsenal. I call it fighting with fire.

If nothing else you can look at supplements not necessarily to correct or avoid a medical problem directly, but simply based on the fact that their plant based sources for the most part contribute to your total alkalinity. I am sure this applies to supplements as in calcium, magnesium, the cruciferous/broccoli IC3's the joint health nutrients as in glucosamine/MSM, your Vitamin C's, etc. although Vitamin C is an acid forming foods. Incidentally in the case of UTI's (Urinary tract infections) vitamin C is highly recommended along with cranberry juice to counter the over alkaline conditions brought on by a UTI. For some reason I have a reservation about this and can't help to wonder whether the body has gone into an alkaline mode to fight the infection. If this is the case I am all wet and the hospitals are all wet when they give you cranberry juice. For now I would lean on the side of a lot of good spring water like the Zephyrhills brand with a little cranberry juice like a 4 to 1 ratio and still go with Vitamin C supplements on a modest dosage.
10. Power foods
Below is a list of Power foods that I felt worthy including them into this feature. I believe the attributes of these particular foods possess the unique mineral properties to sponge the free radicals that are roaming our bodies. Keep in mind one thing and you will read about our views on the sun. The sun as we know produces Vitamin D. Vitamin D works with Calcium and other minerals to make them "more available" Taking in a ton of mineral supplements or even good foods do not necessarily mean your body is going to utilize them.
The same applied to our agricultural experience when for the most part plants and trees received adequate sunlight. They called it the photosynthesis process and there is no question this is a very close brother to human Vitamin D production.
You can't afford not to get adequate sun at the less potent times of day (not between 10 A.M. and 3 P.M.) I personally take in a half an hour a day and in my birthday suit and I rotate my body around to catch every angle. I do coat my body with a generous amount of Aloe Vera gel for a moisturizer and protectant, as I had a bout with skin cancer a few years back, but this has not stopped me from getting enough sun and not one skin cancer has appeared in 5 years now since instituting this process.
11. Calcium
The ultimate regulator of the body. Below is a part of our latest feature on Calcium. The full feature is http://www.blueeyedcurse.com/Calcium.htm
Our full feature has our dietary regimen regarding obtaining enough calcium and the best sources.
The surprising benefits of calcium:
You know you need it for strong bones, but calcium protects your health in other important ways, too. Here is what this amazing mineral can do for you.
Calcium Functions
Calcium is responsible for construction, formation and maintenance of bone and
teeth. This function helps reduce the occurrence of osteoporosis.
Calcium is a vital component in blood clotting systems and also helps in wound healing.
Calcium helps to control blood pressure, nerve transmission, and release of
neurotransmitters.
Calcium is an essential component in the production of enzymes and hormones that regulate digestion, energy, and fat metabolism.
Calcium helps to transport ions (electrically charged particles) across the
membrane.
Calcium is essential for muscle contraction.
Calcium assists in maintaining all cells and connective tissues in the body.
Calcium may be helpful to reduce the incidence of premature heart disease,
especially if adequate intakes of magnesium are also maintained.
Calcium may help to prevent periodontal disease (gum disease).
Calcium helps keep the weight off.
Research suggests that if you don't get enough calcium in your diet, you're
likely to be overweight.
The reason has to do with your body's response to a calcium deficit.
When you're low, your body thinks you're starving and enters emergency
mode.
For those who receive a printed version of this you will have to enter into our website to access the various links that we refer to in the feature. www.blueeyedcurse.com
The author of this work is Bob Martino. My friends call me "Apple Bob" because of my fruit growing past. We owned and operated the Peacedale Farms and Roadside Market in Schodack N.Y. a little south of Albany, New York. If you have any comments or perhaps your own views on some of the subject matter, we would be glad to hear from you and perhaps modify our material somewhat if there are any inaccuracies. Call before 9 P.M. EST 954-922-9181 Sorry no e-mail address, I am getting deluged with Viagra ads now. Someone found out I was 71 years old.
Allied information. Great Feature by Dr. Mercola on Vitamins and Digestion Link below
http://www.mercola.com/2005/apr/30/supplement_safety.htm
Important article on the flu and the immune system. Click the following link Immuneflu.doc
Great Link on the lymphatic network and pH http://www.liferesearchuniversal.com/lymph_ph.html
This
information is intended to heighten awareness of potential health care
alternatives and should not be considered as medical advice. See your qualified
health-care professional for medical attention, advice, diagnosis, and
treatments.